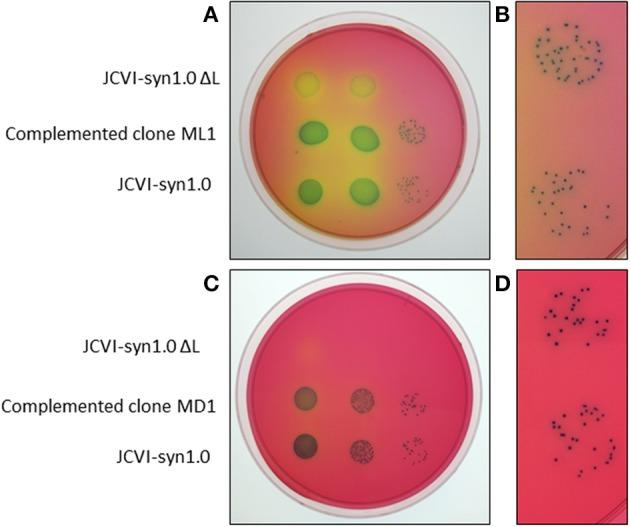
https://cdn.ncbi.nlm.nih.gov/pmc/blobs/fd80/4107850/039d85adb195/fmicb-05-00369-g0006.jpg

利用体外重组设计转座子拯救支原体(mycoplasma)的突变体适应性缺陷。
Rescue of mutant fitness defects using in vitro reconstituted designer transposons in Mycoplasma mycoides.
机构信息
Department of Synthetic Biology and Bioenergy, J. Craig Venter Institute La Jolla, CA, USA.
Department of Synthetic Biology and Bioenergy, J. Craig Venter Institute La Jolla, CA, USA ; Department of Molecular Microbiology and Immunology, University of Missouri Columbia, MO, USA.
出版信息
Front Microbiol. 2014 Jul 23;5:369. doi: 10.3389/fmicb.2014.00369. eCollection 2014.
With only hundreds of genes contained within their genomes, mycoplasmas have become model organisms for precise understanding of cellular processes, as well as platform organisms for predictable engineering of microbial functions for mission-critical applications. Despite the availability of "whole genome writing" in Mycoplasma mycoides, some traditional methods for genetic engineering are underdeveloped in mycoplasmas. Here we demonstrate two facile transposon-mediated approaches for introducing genes into the synthetic cell based on M. mycoides. The marker-less approach involves preparing a fragment containing only a small genomic region of interest with flanking transposase-binding sites, followed by in vitro transposase loading and introduction into the cells. The marker-driven approach involves cloning an open reading frame (ORF) of interest into a vector containing a marker for mycoplasma transformation, as well as sites for transposase loading and random genomic integration. An innovative feature of this construct is to use a single promoter to express the transformation marker and the introduced ORF. The marker-driven approach can be conveniently applied to any exogenous or synthetic gene without any information on the effect of the gene on the strain, whereas the marker-less approach requires that the fragment has a recognizable effect. Using the marker-less method, we found that a region containing the nusG gene rescues a slow growth phenotype of a strain containing a larger deletion encompassing this gene. Using the marker-driven approach, we better defined this finding, thereby establishing that nusG is required for a normal growth rate in synthetic M. mycoides. These methods are suitable for complementation tests to identify genes responsible for assorted functions lacking in deletion mutants. These approaches are also expected to facilitate rapid testing of various natural and engineered genes or gene clusters from numerous sources in M. mycoides.
支原体基因组中仅包含数百个基因,但它们已成为精确理解细胞过程的模式生物,也是可预测地工程改造微生物功能以用于关键任务应用的平台生物。尽管在支原体 M. mycoides 中可实现“全基因组编写”,但一些传统的遗传工程方法在支原体中仍不够发达。在这里,我们展示了两种基于 M. mycoides 的简便转座子介导方法,可将基因引入合成细胞。无标记方法涉及制备仅包含小基因组感兴趣区域的片段,该片段带有侧翼转座酶结合位点,然后在体外加载转座酶并将其引入细胞。标记驱动方法涉及将感兴趣的开放阅读框 (ORF) 克隆到包含支原体转化标记物以及转座酶加载和随机基因组整合位点的载体中。该构建体的一个创新特点是使用单个启动子来表达转化标记物和引入的 ORF。标记驱动方法可以方便地应用于任何外源或合成基因,而无需了解该基因对菌株的影响,而无标记方法则要求该片段具有可识别的作用。使用无标记方法,我们发现包含 nusG 基因的区域可挽救包含更大缺失的菌株的生长缓慢表型,该缺失涵盖了该基因。使用标记驱动方法,我们更好地定义了这一发现,从而确定 nusG 是合成 M. mycoides 中正常生长速率所必需的。这些方法适用于互补测试,以鉴定缺失突变体中缺乏的各种功能的基因。这些方法还预计将促进快速测试来自众多来源的各种天然和工程基因或基因簇在 M. mycoides 中的功能。